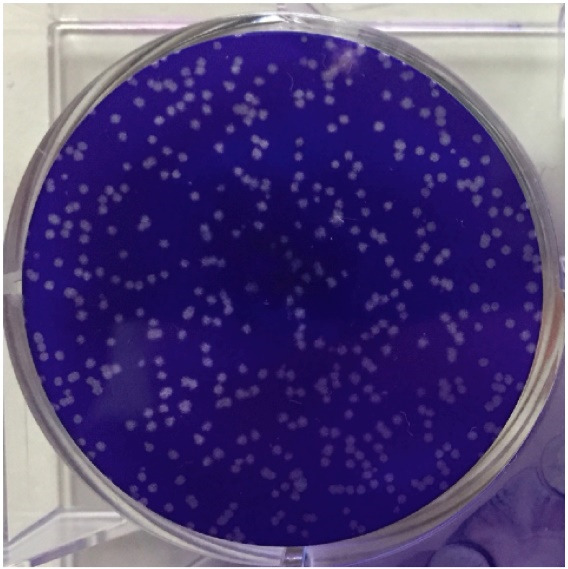
Figure 1.

Abstract
The aryl hydrocarbon receptor (AHR) is known as a sensor for dioxins that mediates their toxicity, and also has important biophysiological roles such as circadian rhythms, cell differentiation and immune responses. 6-formylindolo(3,2-b)carbazole (FICZ), which is derived through the metabolism of L-tryptophan by ultraviolet B irradiation, is one of putative physiological ligands for AHR ( Smirnova et al., 2016 ). It has recently been shown that endogenously-activated AHR signaling modulates innate immune response during viral infection ( Yamada et al., 2016 ). This section describes how to treat mice with FICZ and to infect them with virus.
Keywords: Aryl hydrocarbon receptor, 6-formylindolo(3, 2-b)carbazole, Viral infection, Innate immunity, Interferon response
Background
The role of AHR had so far been investigated mainly on the basis of experiments with dioxin treatment. On the other hand, it has been shown that AHR-mediated signaling is activated by endogenous tryptophan metabolites (FICZ, Kynurenine, etc.), heme metabolites (bilirubin etc.), and eicosanoids (Lipoxin A etc.). In particular, it was demonstrated that FICZ is a physiological high affinity ligand for AHR, and many accumulating reports have shown that FICZ is involved in various basic biological processes including adaptive responses to ultraviolet light, immune responses, genomic instability, and homeostasis of stem cells. Recently, Yamada et al. (2016) demonstrated its role in innate immune response: FICZ treatment in vivo suppresses type I interferon (IFN) production in response to viral infection and promotes levels of viral titer in sera of mice.
Materials and Reagents
0.1-10 μl pipet tips (Thermo Fisher Scientific, Thermo ScientificTM, catalog number: QSP#TF104)
1-200 μl pipet tips (Corning, catalog number: 4845)
100-1,000 μl pipet tips (Corning, catalog number: 4846)
1.5 ml microcentrifuge tubes (Corning, Axygen®, catalog number: MCT-150-A)
1 ml syringe (NIPRO, catalog number: 4987458080104)
27 G hypodermic needle (TERUMO, catalog number: NN-2719S)
Feather disposable scalpel (Sigma-Aldrich, catalog number: Z692395)
Falcon 6-well tissue culture plate (Corning, Falcon®, catalog number: 353046)
C57BL/6NJcl mice (male, 6 weeks of age, purchasable from CLEA Japan, model: C57BL/6NJcl mice)
Vero cells (purchasable from ATCC, catalog number: CCL-81)
6-formylindolo(3,2-b)carbazole (FICZ) (Enzo Life Sciences, catalog number: BML-GR206-0100)
Corn oil (stored at room temperature) (Sigma-Aldrich, catalog number: C8267)
Vesicular stomatitis virus (VSV) (Indiana strain: Kuroda et al., 2016)
Phosphate-buffered saline (PBS) (pH 7.4) (NISSUI PHARMACEUTICAL, catalog number: 05913)
VeriKine-HSTM mouse IFN beta serum ELISA kit (Pestka Biomedical Laboratories, catalog number: 42410)
Dulbecco’s modified Eagle’s medium (DMEM) (‘Nissui’ ) (NISSUI PHARMACEUTICAL, catalog number: 05919)
Methyl cellulose, 4,000 cps (Sigma-Aldrich, catalog number: 19-2930)
Fetal bovine serum (FBS) (Thermo Fisher Scientific, GibcoTM, catalog number: 10437-028)
Acetic acids (KANTO CHEMICAL, catalog number: 01021-70)
Methanol (NACALAI TESQUE, catalog number: 21915-93)
Crystal violet (Sigma-Aldrich, catalog number: C6158)
Formaldehyde (Wako Pure Chemical Industries, catalog number: 063-04815)
FICZ solution (see Recipes)
VSV stock solution (see Recipes)
Fixation solution (see Recipes)
Crystal violet staining solution (see Recipes)
Equipment
Pipettes (PIPETMAN P2) (Gilson, catalog number: F144801)
Pipettes (PIPETMAN P20) (Gilson, catalog number: F123600)
Pipettes (PIPETMAN P1000) (Gilson, catalog number: F123602)
Centrifuge
Deep freezer
Biosafety hood in a biosafety level 3 (BSL3) facility (HITACHI, model: SCV-1303 ECII-AG)
Labnet VX100 vortex (Labnet International, catalog number: 13111-LV2)
Procedure
-
In vivo treatment with FICZ
FICZ is dissolved at 10 mg/ml in corn oil (see Recipes).
Mice are intraperitoneally injected with 200 μl of corn oil (as a negative control) or 10 mg/ml FICZ solution (2 mg per mouse).
-
In vivo infection with VSV
An aliquot of VSV stock is suspended in PBS to 1.5 x 109 PFU/ml.
At 12 h after treatment with FICZ, mice were intraperitoneally infected with 200 μl of PBS (as an uninfected control) or this virus solution (3 x 108 PFU per mouse).
-
Measurement of serum interferon-beta levels and viral titers
At 12 h after infection with VSV, collect blood samples from mouse tail veins by making a cut around 5 mm from the tip of the mouse tail using scalpel blade.
Allow the whole blood to clot by leaving it undisturbed at room temperature for 30 min.
Remove the clot by centrifuging at 1,000 × g for 10 min at 4 °C.
For measurement of serum interferon-beta levels, use VeriKine-HSTM mouse IFN beta serum ELISA kit. ELISA is performed according to the manufacturer’s protocol.
For measurement of serum viral titer, plaque-forming assay is performed. In this assay, 5 x 106 Vero cells on 6-well plate is infected with virus of serum samples for 1 h and overlaid with 2 ml of DMEM containing 2.4% methylcellulose and 5% heat inactivated FBS for 24 h. Plaques (i.e., focus of dead cells) can be more visible by staining live cells through the following method: Cells are fixed for 15 min with 1 ml of fixation solution (see Recipes), and then remove the above-mentioned, overlaid media with running water. Plaques are counterstained with 1 ml of crystal violet solution for 15 min, and washed with running water. A representative image of counterstained plaques is shown in Figure 1.
Figure 1. An image of plaques.
This is the result of VSV infection in Vero cells. One representative well of the 6-well plate is shown. Live cells are stained with crystal violet, while dead cells following viral infection, so-called ‘plaques’, are not stained.
Data analysis
Statistical significance between two samples is determined by Student’s t-test. Each sample is prepared in septuplicate (cf. Figure 2d of Yamada et al. [2016]).
Recipes
-
FICZ solution
Dissolve 10 mg FICZ in 1 ml corn oil at room temperature. Vortexing is required to dissolve completely.
Note: In this experiment, a freshly prepared solution of FICZ is always used without filtration.
-
VSV stock solution
VSV is suspended with PBS to 2.0 x 109 PFU/ml and stored at -80 °C in deep freezer
Notes:
When you thaw a viral stock, you should thaw it on ice.
It is also important not to use it again, because of its possible degradation of virus titers by freeze and thaw action.
-
Fixation solution
Fixation solution is composed of 30% acetic acid and 70% methanol
-
Crystal violet staining solution
Crystal violet staining solution is prepared with PBS containing 0.0005% crystal violet (w/v) and 4% formaldehyde (v/v)
Acknowledgments
This protocol was adapted from Yamada et al. (2016). This was supported by a grant from the Ministry of Health, Labour and Welfare of Japan, the Ministry of Education, Culture, Sports, Science and Technology of Japan (grant-in-aid for scientific research (A) [25253030] and grant-in-aid for scientific research on innovative areas [25115502, 23112701]), the Kato Memorial Bioscience Foundation, the Yasuda Medical Foundation, the Takeda Science Foundation and the Waksman Foundation of Japan to A.T.
Citation
Readers should cite both the Bio-protocol article and the original research article where this protocol was used.
References
- 1.Kuroda M., Fujikura D., Nanbo A., Marzi A., Noyori O., Kajihara M., Maruyama J., Matsuno K., Miyamoto H., Yoshida R., Feldmann H. and Takada A.(2015). Interaction between TIM-1 and NPC1 is important for cellular entry of Ebola virus. J Virol 89(12): 6481-6493. [DOI] [PMC free article] [PubMed] [Google Scholar]
- 2.Smirnova A., Wincent E., Vikström Bergander L., Alsberg T., Bergman J., Rannug A. and Rannug U.(2016). Evidence for new light-independent pathways for generation of the endogenous aryl hydrocarbon receptor agonist FICZ. Chem Res Tpxicol 29: 75-86. [DOI] [PubMed] [Google Scholar]
- 3.Yamada T., Horimoto H., Kameyama T., Hayakawa S., Yamato H., Dazai M., Takada A., Kida H., Bott D., Zhou A. C., Hutin D., Watts T. H., Asaka M., Matthews J. and Takaoka A.(2016). Constitutive aryl hydrocarbon receptor signaling constrains type I interferon-mediated antiviral innate defense. Nat Immunol 17(6): 687-694. [DOI] [PubMed] [Google Scholar]
